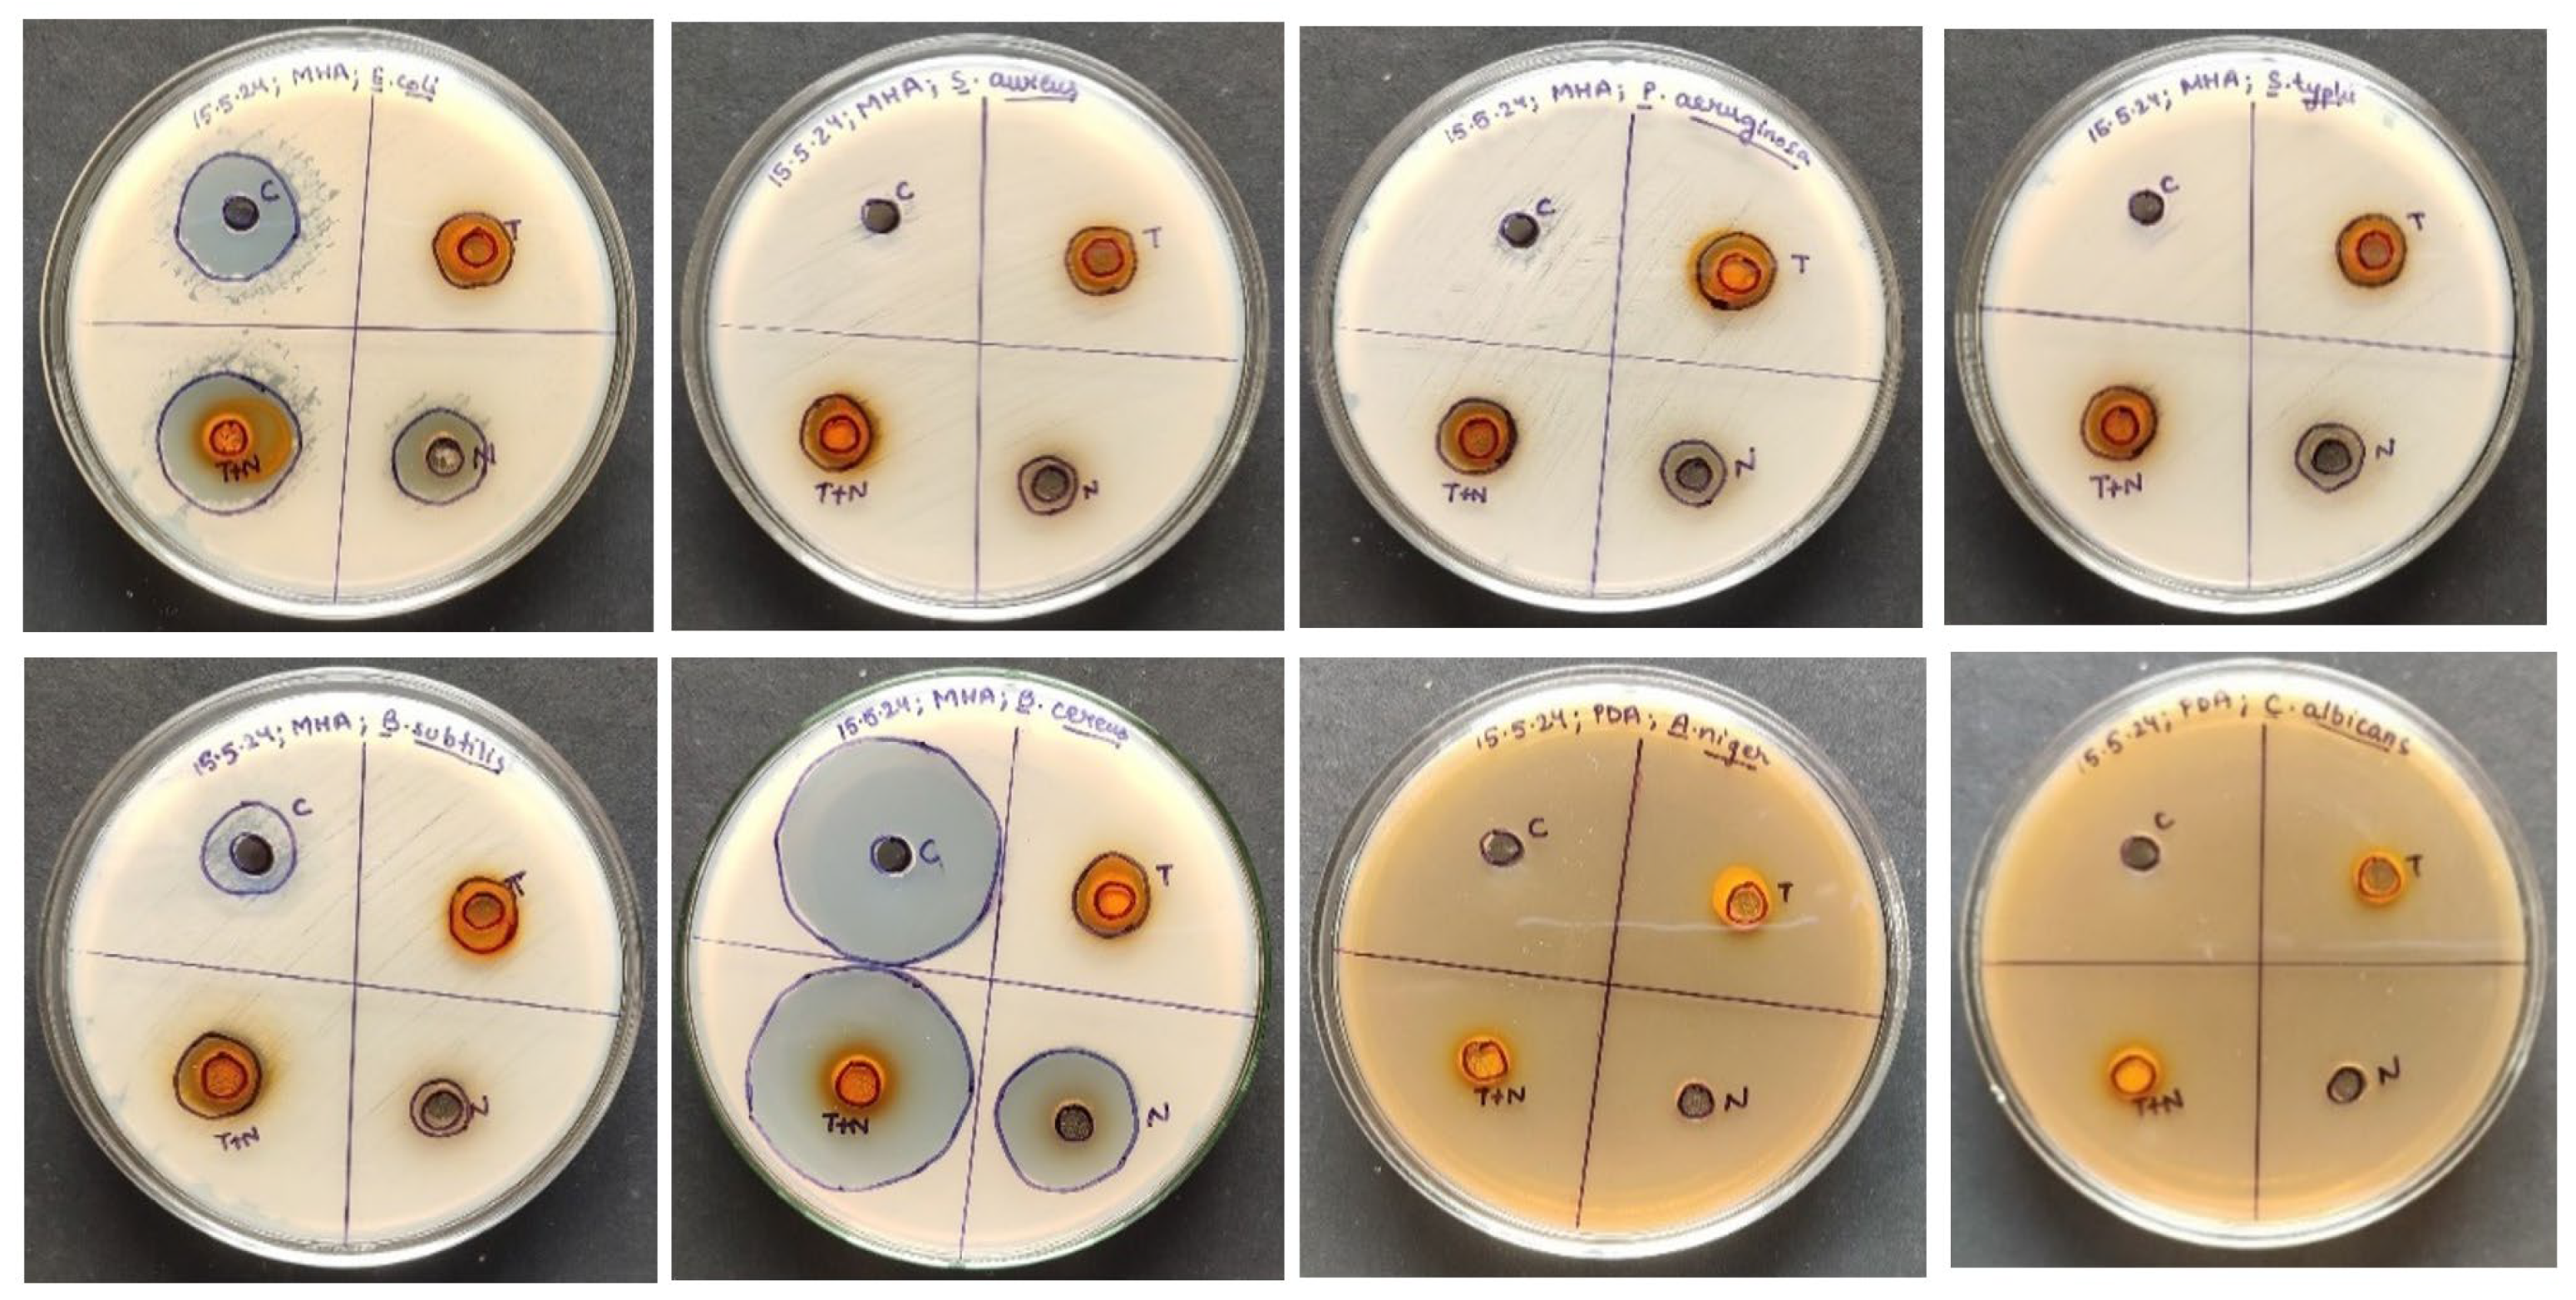
Gels 10 00578 g003

Formulation and Evaluation of Turmeric- and Neem-Based Topical Nanoemulgel against Microbial Infection
Abstract
1. Introduction
2. Results and Discussion
2.1. Antioxidant Activity of Turmeric and Neem Leaf Extract
2.2. Anti-Inflammatory Activity of Turmeric and Neem Leaf Extract
2.3. Antimicrobial Properties of Turmeric and Neem Leaf Extract
2.4. Turmeric- and Neem-Based Nanoemulsion Physicochemical Evaluation
2.4.1. Color, Homogeneity, Phase Separation, Appearance, and pH
2.4.2. Particle Characterization
2.4.3. Instrumental Analysis
2.5. Characterization of Turmeric- and Neem-Based Nanoemulgel
Physicochemical Properties
2.6. Drug–Excipient Interaction Studies
2.7. Drug Permeation In Vitro Study Explaination
2.8. Ex Vivo Mucoadhesive Topical Administration Findings
2.9. Antimicrobial Properties of Nanoemulgel
2.10. Stability Study
3. Conclusions
4. Materials and Methods
4.1. Chemicals, Plants, and Microbial Strains
4.2. Methods
4.2.1. Extraction from Neem Leaves
4.2.2. Extraction from Turmeric Rhizomes
4.2.3. Antioxidant Activity of Hydroalcoholic Extract of Turmeric and Neem Leaves
DPPH Free Radical Scavenging Activity
4.2.4. Anti-Inflammatory Activity of Hydroalcoholic Extract of Turmeric and Neem Leaves
Bovine Serum Albumin Denaturation Activity
4.2.5. Antimicrobial Activity of Hydroalcoholic Extract of Turmeric and Neem Leaves
4.2.6. Preparation and Optimization of Turmeric- and Neem-Based Nanoemulsion
4.2.7. Characterization of Turmeric- and Neem-Based Nanoemulsion
Physicochemical Properties and pH
Particle Characterization
FTIR Analysis
4.2.8. Formulation of Turmeric- and Neem-Based Nanoemulgel
4.2.9. Characterization of Turmeric- and Neem-Based Nanoemulgel
Physical Examination
Rheological Studies
4.2.10. Spreadability of Nanoemulgel
4.2.11. FTIR Analysis
4.2.12. In Vitro Study
4.2.13. Ex Vivo Mucoadhesive Study
4.2.14. Antimicrobial Activity of Turmeric- and Neem-Based Nanoemulgel
4.2.15. Stability Study
4.2.16. Statistical Analysis
Author Contributions
Funding
Institutional Review Board Statement
Informed Consent Statement
Data Availability Statement
Conflicts of Interest
References
- Siafaka, P.I.; Özcan Bülbül, E.; Okur, M.E.; Karantas, I.D.; Üstündağ Okur, N. The application of nanogels as efficient drug delivery platforms for dermal/transdermal delivery. Gels 2023, 9, 753. [Google Scholar] [CrossRef]
- Nawaz, A.; Latif, M.S.; Alnuwaiser, M.A.; Ullah, S.; Iqbal, M.; Alfatama, M.; Lim, V. Synthesis and characterization of chitosan-decorated nanoemulsion gel of 5-fluorouracil for topical delivery. Gels 2022, 8, 412. [Google Scholar] [CrossRef]
- Hamed, R.; Abu Alata, W.A.; Abu-Sini, M.; Abulebdah, D.H.; Hammad, A.M.; Aburayya, R. Development and comparative evaluation of ciprofloxacin nanoemulsion-loaded bigels prepared using different ratios of oleogel to hydrogels. Gels 2023, 9, 592. [Google Scholar] [CrossRef] [PubMed]
- Farooq, U.; Rasul, A.; Zafarullah, M.; Abbas, G.; Rasool, M.; Ali, F.; Ahmed, S.; Javaid, Z.; Abid, Z.; Riaz, H.; et al. Nanoemulsions as novel nanocarrieres for drug delivery across the skin: In-vitro, in-vivo evaluation of miconazole nanoemulsions for treatment of Candidiasis albicans. Des. Monomers Polym. 2021, 24, 240–258. [Google Scholar] [CrossRef]
- Wang, Y.J.; Wang, J.Y.; Wu, Y.H. Application of cellular resolution full-field optical coherence tomography in vivo for the diagnosis of skin tumours and inflammatory skin diseases: A pilot study. Dermatology 2022, 238, 121–131. [Google Scholar] [CrossRef]
- Alkilani, A.Z.; Nasereddin, J.; Hamed, R.; Nimrawi, S.; Hussein, G.; Abo-Zour, H.; Donnelly, R.F. Beneath the Skin: A Review of Current Trends and Future Prospects of Transdermal Drug Delivery Systems. Pharmaceutics 2022, 14, 1152. [Google Scholar] [CrossRef] [PubMed]
- Siafaka, P.I.; Bülbül, E.Ö.; Mutlu, G.; Okur, M.E.; Karantas, I.D.; Okur, N.Ü. Transdermal Drug Delivery Systems and their Potential in Alzheimer’s Disease Management. CNS Neurol. Disord. Drug Targets 2020, 19, 360–373. [Google Scholar] [CrossRef] [PubMed]
- Liu, Y.; Zhu, X.; Ji, S.; Huang, Z.; Zang, Y.; Ding, Y.; Zhang, J.; Ding, Z. Transdermal delivery of colchicine using dissolvable microneedle arrays for the treatment of acute gout in a rat model. Drug Deliv. 2022, 29, 2984–2994. [Google Scholar] [CrossRef]
- Sarheed, O.; Dibi, M.; Ramesh, K.V.; Drechsler, M. Fabrication of alginate-based O/W nanoemulsions for transdermal drug delivery of lidocaine: Influence of the oil phase and surfactant. Molecules 2021, 26, 2556. [Google Scholar] [CrossRef]
- Pavoni, L.; Perinelli, D.R.; Bonacucina, G.; Cespi, M.; Palmieri, G.F. An overview of micro-and nanoemulsions as vehicles for essential oils: Formulation, preparation and stability. Nanomaterials 2020, 10, 135. [Google Scholar] [CrossRef]
- Wang, Y.; Li, M.; Wen, X.; Tao, H.; Wang, K.; Fu, R.; Tao, H.; Wang, F.; Chen, N.; Ni, Y. Conformational changes and the formation of new bonds achieving robust nanoemulsions by electrostatic interactions between whey protein isolate and chondrioitin sulfate. Food Hydrocoll. 2023, 136, 108263. [Google Scholar] [CrossRef]
- Yuan, L.; Pan, M.; Shi, K.; Hu, D.; Li, Y.; Chen, Y.; Qian, Z. Nanocarriers for Promoting Skin Delivery of Therapeutic Agents. Appl. Mater. Today 2022, 27, 101438. [Google Scholar] [CrossRef]
- Falleh, H.; Jemaa, M.B.; Neves, M.A.; Isoda, H.; Nakajima, M.; Ksouri, R. Formulation, physicochemical characterization, and anti—E. coli activity of food-grade nanoemulsions incorporating clove, cinnamon, and lavender essential oils. Food Chem. 2021, 359, 129963. [Google Scholar] [CrossRef]
- Hosny, K.M.; Alhakamy, N.A.; Sindi, A.M.; Khallaf, R.A. Coconut oil nanoemulsion loaded with a statin hypolipidemic drug for management of burns: Formulation and in vivo evaluation. Pharmaceutics 2020, 12, 1061. [Google Scholar] [CrossRef]
- Ojha, B.; Jain, V.K.; Gupta, S.; Talegaonkar, S.; Jain, K. Nanoemulgel: A promising novel formulation for treatment of skin ailments. Polym. Bull. 2022, 79, 4441–4465. [Google Scholar] [CrossRef]
- Sengupta, P.; Chatterjee, B. Potential and future scope of nanoemulgel formulation for topical delivery of lipophilic drugs. Int. J. Pharm. 2017, 526, 353–365. [Google Scholar] [CrossRef]
- Roy, A.; Nishchaya, K.; Rai, V.K. Nanoemulsion-based dosage forms for the transdermal drug delivery applications: A review of recent advances. Expert Opin. Drug Deliv. 2022, 19, 303–319. [Google Scholar] [CrossRef]
- Rai, V.K.; Mishra, N.; Yadav, K.S.; Yadav, N.P. Nanoemulsion as pharmaceutical carrier for dermal and transdermal drug delivery: Formulation development, stability issues, basic considerations and applications. J. Control. Release 2018, 270, 203–225. [Google Scholar] [CrossRef]
- Rai, V.K.; Sharma, A.; Thakur, A. Quality Control of Nanoemulsion: By PDCA Cycle and 7QC Tools. Curr. Drug Deliv. 2021, 18, 1244–1255. [Google Scholar] [CrossRef]
- Rahman, M.M.; Rahaman, M.S.; Islam, M.R.; Hossain, M.E.; Mannan Mithi, F.; Ahmed, M.; Saldías, M.; Akkol, E.K.; Sobarzo-Sánchez, E. Multifunctional therapeutic potential of phytocomplexes and natural extracts for antimicrobial properties. Antibiotics 2021, 10, 1076. [Google Scholar] [CrossRef]
- Dabas, A.; Yadav, P.; Geetanjali; Singh, R. Role of Herbal Medicine in Boosting Immune System. In Role of Herbal Medicines: Management of Lifestyle Diseases; Dhara, A.K., Mandal, S.C., Eds.; Springer Nature: Singapore, 2024; pp. 389–401. [Google Scholar] [CrossRef]
- Srivastava, B.B.; Ripanda, A.S.; Mwanga, H.M. Ethnomedicinal, phytochemistry and antiviral potential of turmeric (Curcuma longa). Compounds 2022, 2, 200–221. [Google Scholar] [CrossRef]
- Bui, V.C.; Le, T.T.; Nguyen, T.H.; Pham, N.T.; Vu, H.D.; Nguyen, X.C.; De Tran, Q.; Hoang, T.; Le Dang, Q.; Lam, T.D. Curcumin-removed turmeric oleoresin nano-emulsion as a novel botanical fungicide to control anthracnose (Colletotrichum gloeosporioides) in litchi. Green Process. Synth. 2021, 10, 729–741. [Google Scholar] [CrossRef]
- Prakash, V.; Akhtar, S.; Kumar, J.; Mishra, S.K.; Pandey, R.R. Neem: The multifaceted and versatile tree. In Current Trends in Medicinal Chemistry; Pandey, R.R., Kumar, J., Eds.; Thanuj International Publishers: Tamil Nadu, India, 2022; pp. 127–138. [Google Scholar]
- Kumar, S.; Singh, N.; Devi, L.S.; Kumar, S.; Kamle, M.; Kumar, P.; Mukherjee, A. Neem oil and its nanoemulsion in sustainable food preservation and packaging: Current status and future prospects. J. Agric. Food Res. 2022, 7, 100254. [Google Scholar] [CrossRef]
- Algahtani, M.S.; Ahmad, M.Z.; Shaikh, I.A.; Abdel-Wahab, B.A.; Nourein, I.H.; Ahmad, J. Thymoquinone loaded topical nanoemulgel for wound healing: Formulation design and in-vivo evaluation. Molecules 2021, 26, 3863. [Google Scholar] [CrossRef] [PubMed]
- Kumar, P.Y.; Parimalam, M.; Kumar, D.; Joseph, E.; David, D.; Vinolia, R. Screening of phytochemicals, Invitro assessment of antioxidant, anti-inflammatory, Tlc profiling and anticancer activity of Aegle Marmelos (L.) leaves. Ann. Rom. Soc. Cell Biol. 2021, 25, 18061–18071. [Google Scholar]
- Ahmed, M.; Marrez, D.A.; Mohamed Abdelmoeen, N.; Abdelmoneem Mahmoud, E.; Ali, M.A.; Decsi, K.; Tóth, Z. Studying the antioxidant and the antimicrobial activities of leaf successive extracts compared to the green-chemically synthesized silver nanoparticles and the crude aqueous extract from Azadirachta indica. Processes 2023, 11, 1644. [Google Scholar] [CrossRef]
- Kaddour, S.M.; Arrar, L.; Baghiani, A. Anti-Inflammatory Potential Evaluation (In-Vitro and In-Vivo) of Arthrophytum scoparium Aerial Part. J. Drug Deliv. Ther. 2020, 10, 213–218. [Google Scholar] [CrossRef]
- Saleem, W.; Sarfraz, B.; Mazhar, S. Combined Effect of Honey, Neem (Azadirachta Indica), and Turmeric against Staphylococcus Aureus and E. Coli Isolated from a Clinical Wound Sample. BioScientific Rev. 2022, 4, 21–44. [Google Scholar] [CrossRef]
- Elsewedy, H.S.; Shehata, T.M.; Soliman, W.E. Tea tree oil nanoemulsion-based hydrogel vehicle for enhancing topical delivery of neomycin. Life 2022, 12, 1011. [Google Scholar] [CrossRef]
- Thomas, L.; Zakir, F.; Mirza, M.A.; Anwer, M.K.; Ahmad, F.J.; Iqbal, Z. Development of Curcumin loaded chitosan polymer based nanoemulsion gel: In vitro, ex vivo evaluation and in vivo wound healing studies. Int. J. Biol. Macromol. 2017, 101, 569–579. [Google Scholar] [CrossRef]
- Deore, S.K.; Surawase, R.K.; Maru, A. Formulation and evaluation of o/w nanoemulsion of ketoconazole. Res. J. Pharma. Dos. Forms Technol. 2019, 11, 264–269. [Google Scholar] [CrossRef]
- Alkhanjaf, A.A.; Athar, M.T.; Ullah, Z.; Umar, A.; Shaikh, I.A. In Vitro and In Vivo Evaluation of a Nano-Tool Appended Oilmix (Clove and Tea Tree Oil) Thermosensitive Gel for Vaginal Candidiasis. J. Funct. Biomater. 2022, 13, 203. [Google Scholar] [CrossRef]
- Liu, H.; Guo, G.; Wang, F.; Tao, H.; Yu, B.; Zhao, H.; Li, J.; Xu, M.; Tao, H.; Cui, B.; et al. Recombinant microgels utilized to formulate green Pickering emulsions. Food Hydrocoll. 2024, 150, 109678. [Google Scholar] [CrossRef]
- Saab, M.; Raafat, K.; El-Maradny, H. Transdermal delivery of capsaicin nanoemulgel: Optimization, skin permeation and in vivo activity against diabetic neuropathy. Adv. Pharm. Bull. 2022, 12, 780. [Google Scholar] [CrossRef] [PubMed]
- Sunthar, T.P.; Marin, E.; Boschetto, F.; Zanocco, M.; Sunahara, H.; Ramful, R.; Kamei, K.; Zhu, W.; Pezzotti, G. Antibacterial and Antifungal properties of composite Polyethylene Materials reinforced with Neem and turmeric. Antibiotics 2020, 9, 857. [Google Scholar] [CrossRef] [PubMed]
- Poorani, G.; Uppuluri, S.; Uppuluri, K.B. Formulation, characterization, in vitro and in vivo evaluation of castor oil based self-nano emulsifying levosulpiride delivery systems. J. Microencapsul. 2016, 33, 535–543. [Google Scholar] [CrossRef] [PubMed]
- Soliman, W.E.; Shehata, T.M.; Mohamed, M.E.; Younis, N.S.; Elsewedy, H.S. Enhancement of curcumin anti-inflammatory effect via formulation into myrrh oil-based nanoemulgel. Polymers 2021, 13, 577. [Google Scholar] [CrossRef]
- Altamimi, M.A.; Hussain, A.; Alshehri, S.; Imam, S.S.; Alnemer, U.A. Development and evaluations of transdermally delivered luteolin loaded cationic nanoemulsion: In vitro and ex vivo evaluations. Pharmaceutics 2021, 13, 1218. [Google Scholar] [CrossRef]
- Gouda, M.; Lv, J.M.; Huang, Z.; Chen, J.C.; He, Y.; Li, X. Bioprobe-RNA-seq-microRaman system for deep tracking of the live single-cell metabolic pathway chemometrics. Biosens. Bioelectron. 2024, 261, 116504. [Google Scholar] [CrossRef]
- Gouda, M.; Huang, Z.; Liu, Y.; He, Y.; Li, X. Physicochemical impact of bioactive terpenes on the microalgae biomass structural characteristics. Bioresour. Technol. 2021, 334, 125232. [Google Scholar] [CrossRef]
- Rehman, A.; Iqbal, M.; Khan, B.A.; Khan, M.K.; Huwaimel, B.; Alshehri, S.; Alamri, A.H.; Alzhrani, R.M.; Bukhary, D.M.; Safhi, A.Y.; et al. Fabrication, in vitro, and in vivo assessment of eucalyptol-loaded nanoemulgel as a novel paradigm for wound healing. Pharmaceutics 2022, 14, 1971. [Google Scholar] [CrossRef] [PubMed]
- Jain, P.; Soni, R.; Paswan, S.K.; Soni, P.K. Ketoconazole laden microemulsion based gel formulation against skin fungal infection. Int. J. App. Pharm. 2023, 15, 49–60. [Google Scholar] [CrossRef]
- Gul, U.; Khan, M.I.; Madni, A.; Sohail, M.F.; Rehman, M.; Rasul, A.; Peltonen, L. Olive oil and clove oil-based nanoemulsion for topical delivery of terbinafine hydrochloride: In vitro and ex vivo evaluation. Drug Deliv. 2022, 29, 600–612. [Google Scholar] [CrossRef] [PubMed]
- Chin, L.Y.; Tan, J.Y.; Choudhury, H.; Pandey, M.; Sisinthy, S.P.; Gorain, B. Development and optimization of chitosan coated nanoemulgel of telmisartan for intranasal delivery: A comparative study. J. Drug Deliv. Sci. Technol. 2021, 62, 102341. [Google Scholar] [CrossRef]
- Shome, S.; Talukdar, A.D.; Upadhyaya, H. Antibacterial activity of curcumin and its essential nanoformulations against some clinically important bacterial pathogens: A comprehensive review. Biotechnol. Appl. Biochem. 2022, 69, 2357–2386. [Google Scholar] [CrossRef] [PubMed]
- Arun, K.J.; Khan, A.; Mahato, N.; Devi, J.; Jawahar, S.S. Sulindac-Loaded Topical Nanoemulgel Formulation and Optimization. Bull. Env. Pharmacol. Life Sci. 2023, 12, 237–245. [Google Scholar]
- Ali, J.; ur Rehman, I.; Bangash, J.A. Phytochemicals content and in-vitro antioxidant properties of Azadirachta indica seeds, leaves and twigs prepared from different extraction techniques. Int. J. Eng. Sci. Technol. 2022, 14, 12–20. [Google Scholar] [CrossRef]
- Khoshraftar, Z.; Shamel, A.; Safekordi, A.A.; Zaefizadeh, M. Chemical composition of an insecticidal hydroalcoholic extract from tea leaves against green peach aphid. Int. J. Environ. Sci. Technol. 2019, 16, 7583–7590. [Google Scholar] [CrossRef]
- Salem, W.H.; Moussa, T.A.; Abou Abouraya, N.L. Cytotoxicity and antibacterial activity of bleached turmeric hydro-alcoholic extract versus sodium hypochlorite as an endodontic irrigant: In vitro study. Braz. Dent. Sci. 2022, 25, e3566. [Google Scholar] [CrossRef]
- Rafiq, M.; Tunio, A.A.; Qureshi, A.S.; Rehman, T.; Bhutto, M.A.; Lasharı, Z. Determination of Phytochemicals, Antimicrobial, Antioxidant and Allelopathic Effects of Fagonia cretica L., collected from Jamshoro, Pakistan. Yuz. Yıl Univ. J. Agric. Sci. 2022, 32, 785–794. [Google Scholar] [CrossRef]
- Donio, M.B.; Remya, R.; Michaelbabu, M.; Uma, G.; Citarasu, T. Characterization and biomedical application of Tetradecamethylcycloheptasiloxane, a silicone-type biosurfactant produced by Streptomyces castaneoglobisporus AJ9 isolated from solar salt works. Indian J. Geomarine Sci. 2022, 51, 694–704. [Google Scholar] [CrossRef]
- Khan, T.A.; Azad, A.K.; Fuloria, S.; Nawaz, A.; Subramaniyan, V.; Akhlaq, M.; Safdar, M.; Sathasivam, K.V.; Sekar, M.; Porwal, O.; et al. Chitosan-coated 5-fluorouracil incorporated emulsions as transdermal drug delivery matrices. Polymers 2021, 13, 3345. [Google Scholar] [CrossRef] [PubMed]
- Malik, M.R.; Al-Harbi, F.F.; Nawaz, A.; Amin, A.; Farid, A.; Mohaini, M.A.; Alsalman, A.J.; Hawaj, M.A.; Alhashem, Y.N. Formulation and characterization of chitosan-decorated multiple nanoemulsion for topical delivery in vitro and ex vivo. Molecules 2022, 27, 3183. [Google Scholar] [CrossRef]
- Ullah, N.; Amin, A.; Farid, A.; Selim, S.; Rashid, S.A.; Aziz, M.I.; Kamran, S.H.; Khan, M.A.; Rahim Khan, N.; Mashal, S.; et al. Development and evaluation of essential oil-based nanoemulgel formulation for the treatment of oral bacterial infections. Gels 2023, 9, 252. [Google Scholar] [CrossRef] [PubMed]
- Le, T.T.; Nguyen, T.K.; Nguyen, V.M.; Dao, T.C.; Nguyen, H.B.; Dang, C.T.; Le, T.B.; Nguyen, T.K.; Nguyen, P.T.; Dang, L.H.; et al. Development and characterization of a hydrogel containing curcumin-loaded nanoemulsion for enhanced in vitro antibacterial and in vivo wound healing. Molecules 2023, 28, 6433. [Google Scholar] [CrossRef]
- Khan, M.A.; Azad, A.K.; Safdar, M.; Nawaz, A.; Akhlaq, M.; Paul, P.; Hossain, M.K.; Rahman, M.H.; Baty, R.S.; El-Kott, A.F.; et al. Synthesis and characterization of acrylamide/acrylic acid Co-polymers and glutaraldehyde crosslinked pH-sensitive hydrogels. Gels 2022, 8, 47. [Google Scholar] [CrossRef]
- Stachowiak, M.; Mlynarczyk, D.T.; Dlugaszewska, J. Wondrous Yellow Molecule: Are Hydrogels a Successful Strategy to Overcome the Limitations of Curcumin? Molecules 2024, 29, 1757. [Google Scholar] [CrossRef] [PubMed]
- Latif, M.S.; Azad, A.K.; Nawaz, A.; Rashid, S.A.; Rahman, M.H.; Al Omar, S.Y.; Bungau, S.G.; Aleya, L.; Abdel-Daim, M.M. Ethyl cellulose and hydroxypropyl methyl cellulose blended methotrexate-loaded transdermal patches: In vitro and ex vivo. Polymers 2021, 13, 3455. [Google Scholar] [CrossRef] [PubMed]
- Kanekar, S.; Rao, S.S.; Yuvarajan, S.; Surya, S.; Rekha, P.D. Linalool-encapsulated alginate microspheres as anti-virulence target against wound infections using In vitro and In vivo models. J. Drug Del. Sci. Technol. 2024, 77, 103848. [Google Scholar] [CrossRef]
- Scomoroscenco, C.; Teodorescu, M.; Raducan, A.; Stan, M.; Voicu, S.N.; Trica, B.; Ninciuleanu, C.M.; Nistor, C.L.; Mihaescu, C.I.; Petcu, C.; et al. Novel gel microemulsion as topical drug delivery system for curcumin in dermatocosmetics. Pharmaceutics 2021, 13, 505. [Google Scholar] [CrossRef]
- Yeo, E.; Chieng, C.J.; Choudhury, H.; Pandey, M.; Gorain, B. Tocotrienols-rich naringenin nanoemulgel for the management of diabetic wound: Fabrication, characterization and comparative in vitro evaluations. Curr. Res. Pharmacol. Drug Discov. 2021, 2, 100019. [Google Scholar] [CrossRef] [PubMed]
- Hettiarachchi, S.S.; Perera, Y.; Dunuweera, S.P.; Dunuweera, A.N.; Rajapakse, S.; Rajapakse, R.M. Comparison of antibacterial activity of nanocurcumin with bulk curcumin. ACS Omega 2022, 7, 46494–46500. [Google Scholar] [CrossRef]
- Rehman, K.u.; Gouda, M.; Zaman, U.; Tahir, K.; Khan, S.U.; Saeed, S.; Khojah, E.; El-Beltagy, A.; Zaky, A.A.; Naeem, M.; et al. Optimization of Platinum Nanoparticles (PtNPs) Synthesis by Acid Phosphatase Mediated Eco-Benign Combined with Photocatalytic and Bioactivity Assessments. Nanomaterials 2022, 12, 1079. [Google Scholar] [CrossRef] [PubMed]
- Sohail, M.; Naveed, A.; Abdul, R.; Khan, H.M.; Khan, H. An approach to enhanced stability: Formulation and characterization of Solanum lycopersicum derived lycopene based topical emulgel. Saudi Pharm. J. 2018, 26, 1170–1177. [Google Scholar] [CrossRef] [PubMed]

| Concentration (µg/mL) | Standard | % RSA (Neem Leaf Extract) | % RSA (Turmeric Extract) | % RSA (Turmeric and Neem Leaf Extract) |
|---|---|---|---|---|
| 20 | 41.8 ± 0.92 | 47.6 ± 0.47 | 50.2 ± 0.59 | 54.1 ± 0.57 |
| 40 | 53.4 ± 1.02 | 58.45 ± 0.7 | 65.4 ± 0.21 | 67.6 ± 0.53 |
| 60 | 68.8 ± 1.26 | 63.71 ± 0.69 | 71.2 ± 0.42 | 73.8 ± 0.49 |
| 80 | 78.6 ± 0.65 | 79.2 ± 0.45 | 84.7 ± 0.68 | 86.7 ± 0.11 |
| 100 | 83.3 ± 0.47 | 92.87 ± 0.54 | 93.7 ± 0.28 | 94.1 ± 0.11 |
| Sr. No. | Pathogens | Zone of Inhibition (cm) | |||
|---|---|---|---|---|---|
| Standard * | Neem Leaf Extract | Turmeric Extract | Turmeric and Neem Leaf Extract | ||
| 1 | Escherichia coli | 1.9 ± 1.041 b | 1.6 ± 0.194 c | 1.3 ± 1.053 d | 2.4 ± 1.064 a |
| 2 | Staphylococcus aureus | - | 1.2 ± 0.364 c | 2.5 ± 0.684 a | 1.6 ± 0.931 b |
| 3 | Pseudomonas aeruginosa | - | 1.8 ± 0.743 b | 2.4 ± 0.674 a | 2.0 ± 1.041 b |
| 4 | Salmonella typhi | - | 1.2 ± 0.764 b | 1.2 ± 0.640 b | 1.4 ± 0.131 a |
| 5 | Bacillus subtilis | 1.5 ± 0.661 a | 1.2 ± 1.163 a | 1.0 ± 0.319 b | 1.4 ± 0.452 a |
| 6 | Bacillus cereus | 3.4 ± 0.423 b | 1.3 ± 0.390 d | 2.4 ± 0.043 c | 3.6 ± 0.672 a |
| 7 | Aspergillus niger | 1.0 ± 0.981 a | 0.7 ± 0.714 bc | 0.5 ± 0.762 d | 0.8 ± 0.925 bc |
| 8 | Candida albicans | 1.1 ± 0.584 a | 0.7 ± 0.261 bc | 0.6 ± 0.431 d | 0.9 ± 0.335 bc |
| Formulation Batch | Color | Phase Separation | Appearance | Homogeneity | pH Range |
|---|---|---|---|---|---|
| A1 | Light Yellowish | Nil | Pellucid | Homogeneous | 5.4 ± 0.13 |
| A2 | Light Yellowish | Nil | Pellucid | Homogeneous | 5.0 ± 0.91 |
| A3 | Light Yellowish | Nil | Pellucid | Homogeneous | 5.7 ± 0.62 |
| A4 | Light Yellowish | Nil | Pellucid | Homogeneous | 5.7 ± 0.73 |
| A5 | Light Yellowish | Nil | Pellucid | Homogeneous | 6.1 ± 0.44 |
| A6 | Light Yellowish | Nil | Pellucid | Homogeneous | 6.3 ± 0.19 |
| B1 | Light Yellowish | Nil | Pellucid | Homogeneous | 5.0 ± 0.53 |
| B2 | Light Yellowish | Nil | Pellucid | Homogeneous | 5.0 ± 0.69 |
| B3 | Yellowish | Nil | Pellucid | Homogeneous | 5.2 ± 0.33 |
| B4 | Yellowish | Nil | Pellucid | Homogeneous | 6.2 ± 0.78 |
| B5 | Yellowish | Nil | Pellucid | Homogeneous | 6.6 ± 0.57 |
| B6 | Yellowish | Nil | Pellucid | Homogeneous | 6.8 ± 0.84 |
| Formulation Batch | Average Droplet Size (nm) | PDI |
|---|---|---|
| A1 | 78.87 ± 2.67 j | 0.4148 ± 0.130 b |
| A2 | 102.3 ± 1.83 i | 0.4355 ± 0.098 b |
| A3 | 119.6 ± 1.15 h | 0.3261 ± 0.055 b |
| A4 | 139.3 ± 0.81 g | 0.256 ± 0.032 b |
| A5 | 242.3 ± 2.56 f | 0.4787 ± 0.023 b |
| A6 | 278.1 ± 2.31 e | 0.2664 ± 0.221 bc |
| B1 | 80.4 ± 2.35 j | 0.1569 ± 0.107 c |
| B2 | 244.8 ± 0.89 f | 0.65772 ± 0.238 ab |
| B3 | 308.9 ± 2.53 d | 0.2542 ± 0.201 bc |
| B4 | 472.1 ± 2.82 c | 0.7557 ± 0.112 a |
| B5 | 811.5 ± 1.32 b | 0.661 ± 0.079 a |
| B6 | 1768 ± 1.89 a | 0.3541 ± 0.041 b |
| Formulation Batch | Color | Consistency | Homogeneity | pH | Viscosity (mPa·S) | Spreadability (g·cm/s) |
|---|---|---|---|---|---|---|
| F1 | Yellowish | Good | Excellent | 6.13 ± 0.01 a | 48,072 ± 5 a | 32 ± 0.5 a |
| F2 | Yellowish | Good | Excellent | 6.3 ± 0.05 b | 54,284 ± 7 b | 34 ± 0.2 b |
| F3 | Yellowish | Good | Excellent | 6.8 ± 0.05 d | 673,094 ± 3 c | 33 ± 0.3 c |
| F4 | Yellowish | Good | Excellent | 6.6 ± 0.03 c | 73,127 ± 8 d | 30 ± 0.5 d |
| SI No. | Oil Phase (% v/v) | Turmeric Extract (%w/v) | Neem Leaf Extract (%w/v) | Surfactant (% v/v) | Co-surfactant (% v/v) | Carbopol 934 (% w/w) | Triethanolamine | Distilled Water (% v/v) |
|---|---|---|---|---|---|---|---|---|
| A1 | 1 | 1 | 1 | 2 | 1 | 1 | q.s. | Upto 50 mL |
| B1 | 1 | 1 | 1 | 4 | 1 | 1 | q.s. | Upto 50 mL |
| Formulation | Viscosity (mPa·S) | Mucoadhesive Force (N) |
|---|---|---|
| Commercial gel | 34,284 ± 7 c | 0.748 ± 0.033 c |
| A1 (Turmeric- and neem-based gel) | 51,317 ± 8 b | 2.235 ± 0.120 b |
| B1 (Turmeric- and neem-based gel) | 54,251 ± 4 a | 2.421 ± 0.128 a |
| Sr. No. | Pathogens | Zone of Inhibition (cm) | ||
|---|---|---|---|---|
| Commercial Gel | Turmeric- and Neem-Based Nanoemulgel (A1) | Turmeric and Neem Nanoemulgel (B1) | ||
| Antibacterial activity | ||||
| 1 | Escherichia coli | - | 3.2 ± 0.672 b | 3.4 ± 0.762 a |
| 2 | Staphylocccus aureus | - | 3.4 ± 0.661 a | 3.3 ± 0.931 a |
| 3 | Pseudomonas aeroginosa | - | 1.3 ± 0.473 a | 1.3 ± 0.431 a |
| 4 | Salmonella typhi | - | 1.3 ± 0.264 a | 1.3 ± 0.440 a |
| 5 | Bacillus subtilis | - | 1.2 ± 0.163 a | 1.1 ± 0.319 b |
| 6 | Bacillus cereus | - | 3.4 ± 0.290 a | 3.2 ± 0.843 a |
| Antifungal activity | ||||
| 7 | Aspergillus niger | 1.4 ± 0.294 b | 2.4 ± 0.416 b | 2.7 ± 0.649 a |
| 8 | Candida albicans | 1.4 ± 0.682 b | 3.2 ± 0.068 a | 2.8 ± 0.301 b |
| Formulation Batch | Color | Consistency | Homogeneity | pH | Viscosity (mPa·S) | Spreadability (g·cm/s) |
|---|---|---|---|---|---|---|
| A1 | Yellowish | Good | Excellent | 6.1 ± 0.4 a | 58,10 ± 2.00 b | 31.12 ±3.1 b |
| B1 | Yellowish | Good | Excellent | 6.3 ± 0.2 a | 61,11 ± 0.04 a | 33.25 ± 2.2 a |
| SI No. | Oil Phase (% v/v) | Turmeric Extract (%w/w) | Neem Leaf Extract (%w/w) | Surfactant: Co-Surfactant 2:1 | Distilled Water (% v/v) | |
|---|---|---|---|---|---|---|
| Surfactant (% v/v) | Co-Surfactant (% v/v) | |||||
| A1 | 1 | 1 | 1 | 2 | 1 | Upto 50 mL |
| A2 | 1 | 1 | 1 | 3 | 1.5 | Upto 50 mL |
| A3 | 1 | 1 | 1 | 4 | 2 | Upto 50 mL |
| A4 | 1 | 1 | 1 | 5 | 2.5 | Upto 50 mL |
| A5 | 1 | 1 | 1 | 6 | 3 | Upto 50 mL |
| A6 | 1 | 1 | 1 | 7 | 3.5 | Upto 50 mL |
| SI No. | Oil Phase (% v/v) | Turmeric Extract (%w/w) | Neem Leaf Extract (%w/w) | Surfactant: Co-surfactant (4:1) | Distilled Water (% v/v) | |
|---|---|---|---|---|---|---|
| Surfactant (% v/v) | Co-Surfactant (% v/v) | |||||
| B1 | 1 | 1 | 1 | 4 | 1 | Upto 50 mL |
| B2 | 1 | 1 | 1 | 6 | 1.5 | Upto 50 mL |
| B3 | 1 | 1 | 1 | 48 | 2 | Upto 50 mL |
| B4 | 1 | 1 | 1 | 10 | 2.5 | Upto 50 mL |
| B5 | 1 | 1 | 1 | 12 | 3 | Upto 50 mL |
| B6 | 1 | 1 | 1 | 14 | 3.5 | Upto 50 mL |
| Constituents | F1 | F2 | F3 | F4 |
|---|---|---|---|---|
| Carbopol 934 (% w/w) | 0.5 | 1 | 1.5 | 2 |
| Triethanolamine | 0.1 mL | 0.1 mL | 0.1 mL | 0.1 mL |
| Distilled water | q.s. | q.s. | q.s. | q.s. |
Disclaimer/Publisher’s Note: The statements, opinions and data contained in all publications are solely those of the individual author(s) and contributor(s) and not of MDPI and/or the editor(s). MDPI and/or the editor(s) disclaim responsibility for any injury to people or property resulting from any ideas, methods, instructions or products referred to in the content. |
© 2024 by the authors. Licensee MDPI, Basel, Switzerland. This article is an open access article distributed under the terms and conditions of the Creative Commons Attribution (CC BY) license (https://creativecommons.org/licenses/by/4.0/).
Share and Cite
Giri, S.; Chakraborty, A.; Mandal, C.; Rajwar, T.K.; Halder, J.; Irfan, Z.; Gouda, M.M. Formulation and Evaluation of Turmeric- and Neem-Based Topical Nanoemulgel against Microbial Infection. Gels 2024, 10, 578. https://doi.org/10.3390/gels10090578
Giri S, Chakraborty A, Mandal C, Rajwar TK, Halder J, Irfan Z, Gouda MM. Formulation and Evaluation of Turmeric- and Neem-Based Topical Nanoemulgel against Microbial Infection. Gels. 2024; 10(9):578. https://doi.org/10.3390/gels10090578
Chicago/Turabian StyleGiri, Sumon, Anhic Chakraborty, Chiranjit Mandal, Tushar Kanti Rajwar, Jitu Halder, Zainab Irfan, and Mostafa M. Gouda. 2024. "Formulation and Evaluation of Turmeric- and Neem-Based Topical Nanoemulgel against Microbial Infection" Gels 10, no. 9: 578. https://doi.org/10.3390/gels10090578
APA StyleGiri, S., Chakraborty, A., Mandal, C., Rajwar, T. K., Halder, J., Irfan, Z., & Gouda, M. M. (2024). Formulation and Evaluation of Turmeric- and Neem-Based Topical Nanoemulgel against Microbial Infection. Gels, 10(9), 578. https://doi.org/10.3390/gels10090578

